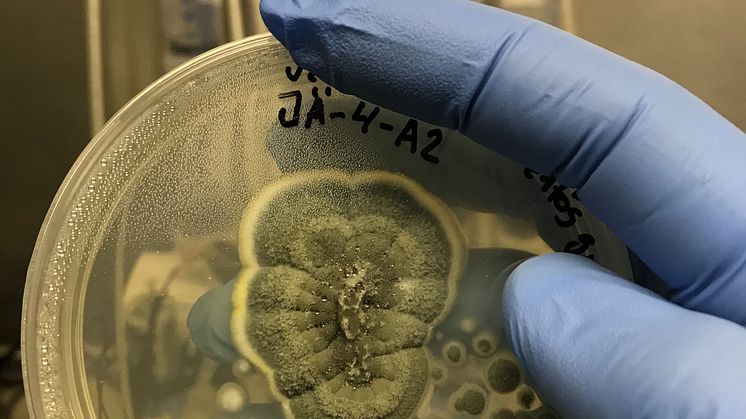

Ny turistattraktion i Axmar bruk: Talande digital guide i Hyttan
Sommaren 2024 erbjuder Axmar bruk i norra Gästrikland en ny upplevelse för besökare. Den gamla hyttan har uppgraderats med en digital installation. Genom en QR-kod kan besökare gratis utforska Hyttans historia via mobilen. En 8-minuters berättelse av Sören Calleberg levandegör brukets historia från 1671 till idag. Den digitala guiden är en del av Pixelvoice, som skapar interaktiva presentationer.